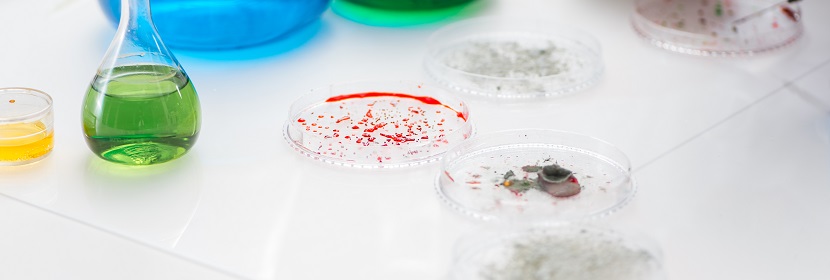
化學試劑葡萄糖檢測

丁二酮肟(二甲基乙二醛肟)檢測
健明迪檢測提供的丁二酮肟(二甲基乙二醛肟)檢測,檢測項目 丁二酮肟含量(C4H8N2O2)、 熔點范圍、 乙醇溶解試驗、 灼燒殘,檢測標準 HG/T3450-1999化學試劑丁二酮肟(二甲基乙二醛肟) GB/T,具有CMA,CNAS資質。

丁二酮肟(二甲基乙二醛肟)檢測 檢測項目
丁二酮肟含量(C4H8N2O2)、
熔點范圍、
乙醇溶解試驗、
灼燒殘渣(以硫酸鹽計);
丁二酮肟(二甲基乙二醛肟)檢測 檢測介紹
化學試劑丁二酮肟(二甲基乙二醛肟)為白色針狀結晶或粉末,不溶于水,溶于乙醇,用于鎳的檢定和測定,從鈷及其他金屬中分離鎳,從錫、金、錸、銥中分離鈀等,氰化物、鎳、鈀的光度測定。
健明迪檢測可以提供丁二酮肟(二甲基乙二醛肟)檢測服務,報告具有CMA和CNAS資質。
健明迪檢測可以提供丁二酮肟(二甲基乙二醛肟)檢測服務,報告具有CMA和CNAS資質。
丁二酮肟(二甲基乙二醛肟)檢測 檢測標準
HG/T 3450-1999 化學試劑 丁二酮肟(二甲基乙二醛肟)
GB/T 603-88 化學試劑 試驗方法中所用制劑及制品的制備
GB/T617-88化學試劑 熔點范圍測定通用方法
GB/T 619-88化學試劑 采樣及驗收規則
GB/T 6682-92 分析實驗室用水規格和試驗方法(neq ISO 3696:1987)
GB/T 9741-88 化學試劑 灼燒殘渣測定通用方法(eqvISO 6353-1:1987)
GB 15346-94 化學試劑 包裝及標志
GB/T 603-88 化學試劑 試驗方法中所用制劑及制品的制備
GB/T617-88化學試劑 熔點范圍測定通用方法
GB/T 619-88化學試劑 采樣及驗收規則
GB/T 6682-92 分析實驗室用水規格和試驗方法(neq ISO 3696:1987)
GB/T 9741-88 化學試劑 灼燒殘渣測定通用方法(eqvISO 6353-1:1987)
GB 15346-94 化學試劑 包裝及標志